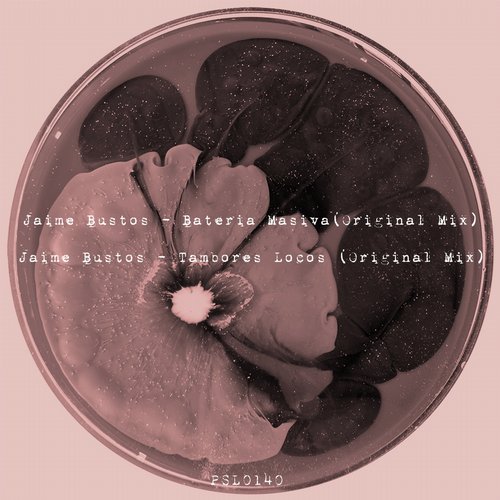
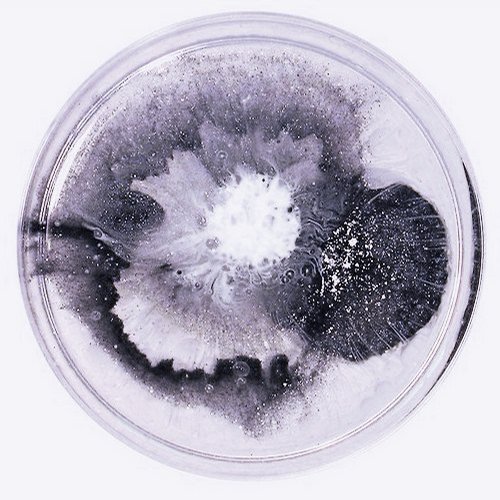

Posts Tagged "Psicodelica"
Music Genres
- Album
- Ambient / Downtempo
- Bass Music
- Breakbeat
- Breaks
- Deep
- Deep House
- Deep Techno
- Disco
- Discography
- Drum & Bass
- Dub Techno
- Dubstep
- Dutch/Electro House
- Electro
- Electronic
- Experimental
- Future Bass
- Garage
- Glitch Hop
- Hardstyle / Hardcore
- Hip-Hop
- House
- IDM
- Indie Dance
- Jazz / Soul
- Lounge / Chillout
- Midtempo
- Minimal
- Moombahton
- Oldies!
- Progressive
- Progressive House
- Psychedelic
- Rock
- Tech House
- Techno
- Trance
- Trap
TOP Compilations
Chat&Request
| Name: | |
| Email: | |
| For: |  |
|
Mail will not be published
|
-
( Sending... )
-
Alex Fireman(2017/12/19)jankel, here http://themusicfire.net/techno/amandra-dame-de-bahi
-
spaceloop(2017/12/19)good morning!
possible to reup this one?
http://themusicfire.net/ambient_downtempo/autre-monde-vigilant-dreams -
BATER(2017/12/19)Don’t forget to reup this
http://themusicfire.net/ambient_downtempo/perfume-advert-foreverware
and this
http://themusicfire.net/house/kerri-chandler-dj-kicks
Thanks for the great job guys! -
zolya(2017/12/18)Please, upload this D-Pulse – Get Lost (Remixes) EP https://www.traxsource.com/title/909337/get-lost-remixes
-
Bob(2017/12/16)all of SNTS and JUDAS previously vinyl only releases already on here are now available digitally. would love to see them here, thanks!
https://sntsrecords.bandcamp.com/music
https://judas9x9.bandcamp.com/ -
WAZ(2017/12/16)anyway we can get an upload for this? https://itunes.apple.com/us/album/barclay-crenshaw-revisited/1314614668
-
WAZ(2017/12/16)anyway we can this? https://solselectas.bandcamp.com/album/mali-edits
-
jankel(2017/12/15)Please upload Amandra – Dame De Bahi
-
Siico(2017/12/15)Hello guys !
Could you re upload this wonderfull EP plz ?
http://themusicfire.net/house/dense-pika-colt-ep
Thx for all you are the best ! -
tasse tee(2017/12/15)(im stupid this is a free download)
Latest Exclusives
Latest releases
- VA – You Can Trust A Moustache With A Moustache Vol 6
- VA – Secret Weapons Part 18
- Unbekannt – Primordial Beats
- Tjade, Kara Okay – Holding On / You Make Me Say
- TiM TASTE, Phoenix Movement – Lost
- Soulfreq – Gonna Be Alright
- VA – Efunk, Vol. 5
- Simon Hinter – You Know What
- Patch Control – Extinction Of Species
- NX1 – Deprogramation EP
Latest comments
- oky on Fiorious – Midnight
- rOXOrR2 on S.A.M. – Prolific Trilogy 009.3
- piggybearsv on Arnaud Rebotini – 120 Battements Par Minute – Original Soundtrack
- duty on Aura Safari – Wave Riding
- piggybearsv on David Carretta – KEYI MAGAZINE (Sonic Reflections: A Charity Compilation)

![Aux 88 Presents Black Tokyo – EP [VINYL] Aux 88 Presents Black Tokyo – EP [VINYL]](http://themusicfire.net/wp-content/uploads/2022/12/R-2187719-1287736754.jpg)
![Aux 88 – Mad Scientist [CD] Aux 88 – Mad Scientist [CD]](http://themusicfire.net/wp-content/uploads/2022/12/Wbc98Qh.jpg)
![Lawrence – Epiphany [VINYL] Lawrence – Epiphany [VINYL]](http://themusicfire.net/wp-content/uploads/2022/12/451247.jpg)
![Benjamin Long – LTDBLBL011 [Hi-RES] Benjamin Long – LTDBLBL011 [Hi-RES]](http://themusicfire.net/wp-content/uploads/2022/12/2O91E5N.jpg)
![Caruan – Diaframma E.P. [VINYL] Caruan – Diaframma E.P. [VINYL]](http://themusicfire.net/wp-content/uploads/2022/12/R-23085146-1651485875-2911.jpg)
![Bees – Hi Keke [VINYL] Bees – Hi Keke [VINYL]](http://themusicfire.net/wp-content/uploads/2022/09/R-18791797-1622161862-2078.jpg)


![Andrey Djackonda – Brom EP [VINYL] Andrey Djackonda – Brom EP [VINYL]](http://themusicfire.net/wp-content/uploads/2022/08/R-23320547-1655983452-2263.jpg)
![Matt John – Joker Family Park One [VINYL] Matt John – Joker Family Park One [VINYL]](http://themusicfire.net/wp-content/uploads/2022/08/R-23719415-1656424944-2160.jpg)
![VA – Federation Of Rytm I [Hi-RES] VA – Federation Of Rytm I [Hi-RES]](http://themusicfire.net/wp-content/uploads/2022/02/R-21695377-1641917831-1345.jpg)
![VA – Soma Quality Recordings vol.1-6 (1994-1999) [Hi-RES] VA – Soma Quality Recordings vol.1-6 (1994-1999) [Hi-RES]](http://themusicfire.net/wp-content/uploads/2022/02/MyCollages.jpg)




